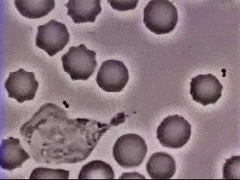

'생명이 없는 음식은 생명의 양식이 될 수 없다.' 라는 말이 있습니다

소는 야생에서 풀을 먹는 동물로 20~30년을 산다고 합니다
하지만 풀이 아닌 가공된 탄수화물과 지방이 풍부한 사료를 먹는 소들은 불과 3살도 되기 전에 성체가 되고
사는 동안 비만과 여러 질병에 시달리게 되며 20~30년은 족히 살 수 있는 소의 수명은
짧게는 2년까지 줄어든 것으로 나타났습니다
이는 생명이 있는 음식이 아닌 죽은 음식을 먹었기 때문입니다

인간 역시 몸에 맞지 않은 음식인 정제된 탄수화물을 먹기 시작하면서 여러 부작용이 생기게 되었습니다
불과 100년 전까지만 해도 당뇨병은 의사가 평생 한 번 보기 어려운 질병이었지만
현재 전 세계 당뇨병 유병 인구는 무려 4억 6천만 명에 이르고 있고, 비만 인구 역시 폭발적으로 증가하고 있습니다
이에 많은 영양학자들은 100년 사이에 벌어진 가장 큰 변화로 정제된 탄수화물 섭취량의 증가를 꼽습니다
정제된 탄수화물은 식이섬유가 없기 때문에 혈당 수치를 매우 빠르게 높이게 됩니다
이는 결국 저혈당증과 허기를 자극해 과식을 유발하게 되고
정제된 탄수화물을 섭취하여 늘어난 혈당은 설탕물처럼 피를 끈적끈적하게 만들어 혈액의 흐름을 방해하고
혈관 내벽에 달라붙어 혈관을 손상시키게 됩니다
그 결과 비만과 당뇨병뿐만이 아니라 갖가지 암, 심혈관질환, 뇌질환을 일으키게 됩니다
때문에 아프지 않고 건강한 삶을 살기 위해서는 정제된 탄수화물을 줄일 필요가 있으며
특히 다음과 같은 증상이 나타난다면 단 음식을 줄일 필요가 있습니다.

단 음식을 줄이라는 몸의 신호
1. 체중 증가
설탕, 흰 밀가루, 흰쌀밥과 같은 정제된 탄수화물은 열량도 높고, 가공이 된 만큼 소화흡수가 빨라서
먹는 즉시 빠른 속도로 혈당을 상승시키게 됩니다.
이때 인체는 혈당 상승에 대한 반작용으로 췌장에서 혈당을 낮추는 인슐린이라는 호르몬을 분비합니다.
그런데 인슐린은 혈당을 낮추는 기능 외에도 초과된 탄수화물을 지방으로 전환시켜 지방조직에 저장하는 역할을 합니다.

즉, 탄수화물을 지나치게 많이 먹으면 "인슐린" 이 지방세포에게 "지방을 저장하라"는 지시를 한다는 것입니다.
뿐만 아니라 혈중 인슐린 수치가 높으면 저장된 지방을 꺼내서 에너지원으로 이용할 수 없게 만들기 때문에
정제된 탄수화물을 지속적으로 과다하게 섭취할 경우 지방의 축적으로 체중이 증가할 뿐만 아니라 비만이 지속되기 때문에
체중이 증가한 경우에는 운동보다도 정제된 탄수화물 섭취량을 제한하는 것이 매우 중요합니다
2. 자주 아프다
정제된 탄수화물은 면역력 도둑이라고도 불립니다.
면역세포 백혈구는 혈관을 타고 온몸을 구석구석 돌아다니면서 혈액과 조직에서 이물질을 잡아먹거나 항체를 형성해
감염으로부터 신체를 보호하는 역할을 합니다.
하지만 당분을 과다 섭취하면, 바이러스들에게 먹을거리를 풍부하게 제공하고, 백혈구의 세균 파괴 능력을 떨어뜨립니다.
연구에 따르면 설탕 100g 섭취 시 백혈구의 반응성을 40%로 감소시키며, 면역체계가 최대 4-5시간 동안 비활성화되는 것으로 나타났습니다.
이로 인해 우리 몸은 감기나 독감뿐 아니라 암과 같은 큰 질병에도 취약해집니다.
3. 기억력 저하

‘신경학 저널’에 발표된 연구에 따르면 혈액 속에 당이 많은 사람들은 기억력에 문제가 발생할 수 있는 것으로 나타났습니다.
연구진은 건강한 성인 141명(평균연령 63세)을 대상으로 단기와 장기 혈당을 측정하고 기억력 테스트를 실시한 결과,
혈당이 낮은 그룹이 높은 그룹에 비해 기억력 테스트 성적이 우수한 것으로 나타났으며
이와 함께 혈당수치 상위 그룹은 하위 그룹에 비해 해마의 크기가 작은 것으로 밝혀졌습니다.
해마의 크기가 줄어들면 치매 발생 위험이 높을 수 있다는 연구 결과 역시 있으므로
기억력이 예전 같지 않다면 단 음식을 확 줄이는 것이 도움이 될 수 있습니다.
4. 충치가 발생한다
평소 충치가 많다면 정제된 탄수화물을 너무 많이 먹고 있다는 증거일 수 있습니다.
국제치과연구협회에서 빠르게 소화되는 정제된 탄수화물(흰 빵, 크래커, 비스킷, 프레첼 등)과 서서히 소화되는 탄수화물(통곡물, 콩류 등) 식품이 구강 건강에 어떤 영향을 주는지 비교한 결과,
빠르게 소화되는 가공식품은 입안에서 아밀라아제에 의해 분해되어 충치 위험을 증가시키는 반면,
통곡물은 오히려 치주질환과 구강암 위험을 감소시킨 것으로 나타났습니다.
뿐만 아니라 충치는 혈당이 잘 조절되지 않는 성인 당뇨병환자에서 흔하게 발생하는데,
고혈당으로 침의 당도가 높아지게 되면 입안의 미생물이 번식하여 입 냄새는 물론 충치와 치아 상실로도 이어지는 치주질환까지 유발할 수 있습니다.
5. 자주 우울하거나 불안하다
단 음식을 먹을 때 뇌에서는 ‘세로토닌’이라는 신경전달물질이 활발하게 분비됩니다.
이로 인해 기분이 좋아지는 느낌을 받지만 금방 세로토닌이 부족해져서 불안이나 우울감이 강화되는 경향이 있습니다.
그래서 본능적으로 좋은 기분을 지속적으로 유지하기 위해 당을 계속 섭취하게 됩니다.
하지만 계속 당에 의존할 경우 뇌는 당분에 대한 중독성을 갖게 되고 당분을 섭취하지 않으면 짜증과 함께 스트레스에 쉽게 노출되게 됩니다.
6. 뼈가 약해진다
우리의 혈액은 항상 pH 7.2-7.4의 약알칼리성을 유지하게 되어있지만 단 음식을 많이 섭취하게 되면 혈액은 산성 상태가 됩니다.
그러면 이를 중화하기 위해 우리 몸은 알칼리 성분을 몸에서 빼내게 되는데 이때 사용되는 알칼리 성분이 바로 뼛속 칼슘이며
칼슘이 결핍되면 골다공증과 같은 건강 문제로 이어질 수 있습니다.
7. 피부 트러블이 생긴다
연구에 따르면, 설탕을 자주 먹는 사람은 여드름 발병 빈도가 30% 더 높은 것으로 나타났습니다.
설탕 등 정제된 탄수화물은 혈류로 빠르게 흡수되어, 혈당 수치를 빠르게 높이게 되고 혈당이 상승하면 인슐린도 높아지는데
인슐린은 안드로겐 호르몬을 활성화하고, 인슐린 유사 성장 인자 (IGF-1)을 증가시키게 되고
이것은 피부 세포를 더 많이 자극하여, 피지 생성을 증가시켜 여드름을 발생시킵니다.
또한 설탕 등 당류를 과다 섭취하면 피부를 윤택하게 보이도록 하는 단백질인 콜라겐의 합성을 방해하기 때문에 피부의 탄력성이 떨어지고 남보다 일찍 주름이 생기게 됩니다.

반대로 설탕 섭취량을 줄이면 여드름이 줄어들고 피부의 탄력도 되살아 납니다.
영국 브라이턴에 사는 여성 에미 사운더스는 15년동안 여드름에 시달렸다고 하는데요.
정제된 탄수화물을 끊자 좀처럼 사라지지 않던 여드름이 사라지고 피부결이 좋아졌다고 합니다.
탄수화물 중독에서 벗어나기 위해서는 우선 흰쌀밥이나 흰 빵, 시리얼과 같은 정제 탄수화물보다는 현미나 귀리(오트밀), 통곡물 빵과 같은 정제되지 않은 탄수화물을 선택해야 합니다.
정제되지 않은 탄수화물은 혈당을 천천히 올리기 때문에 인슐린이 과하게 분비되지 않습니다
또 한번 먹는 양이 적으면 혈당이 급격히 올라가지 않기 때문에 인슐린을 크게 자극하지 않습니다.
때문에 한 끼 식사마다 밥의 양을 줄이고, 반찬을 조금 더 먹는다면 효과적으로 탄수화물을 줄일 수 있습니다.
다만 끼니를 거르게 되면 혈당이 뚝 떨어지면서 본능적으로 혈당을 빠르게 높이는 단 음식을 찾게 되는 경향이 있으므로
매끼 거르지 않은 것이 탄수화물 중독에서 벗어나는 좋은 방법입니다.
또한 먹는 순서를 식이섬유-단백질-탄수화물 순으로 바꾸면 혈당이 크게 상승하는 것을 막을 수 있으며
또 식이섬유와 단백질을 먼저 먹게 되면 포만감이 잘 생기고, 이후 먹는 탄수화물 섭취량을 줄일 수 있습니다.
몸에 대한 지식도 없고, 병원도 약도 없던 고대부터 현재까지 인류가 생존할 수 있었던 이유는
증상이라는 몸의 신호에 맞춰 살아왔기 때문입니다.
단 음식으로 인해 오늘 알려드린 증상이 나타났을 때는 정제도니 음식, 즉 죽은 음식을 끊는다면 여러 질병에서 벗어날 수 있을 겁니다.
오늘도 함께해 주셔서 감사합니다.
더 유익한 정보를 찾아뵙겠습니다.
건강의 차이가 곧 인생의 차이다.
2023.05.12 - [건강 정보] - 혈액 순환이 안될 때 몸이 보내는 신호 혈액 순환 방법
혈액 순환이 안될 때 몸이 보내는 신호 혈액 순환 방법
옛말에 고인 물은 반드시 썩게 된다는 적수역부(積水易腐)라는 말이 있습니다. 흐르는 강물은 생명을 품고 있고 건강하지만 생명의 근원인 물도 고이면 썩게 됩니다. 혈액 역시 잘 순환한다면
powerofhealth.tistory.com
2023.05.08 - [건강 정보] - 신장이 안 좋으면 나타나는 증상
신장이 안 좋으면 나타나는 증상
신장은 우리 몸의 정수기로써 몸의 노폐물을 걸러내는 여과기 역할을 하며 전해질, 혈압, 체액을 조절하기 때문에 전반적인 건강에 있어 매우 중요한 역할을 합니다. 하지만 고령화 사회로 진입
powerofhealth.tistory.com
'건강 정보' 카테고리의 다른 글
| 간에 좋은 음식 : 간기능 저하 간 건강 (2) | 2023.05.27 |
|---|---|
| 약 없이 혈압 낮추는 방법! 혈압 낮추는 방법 (0) | 2023.05.27 |
| 혈액 순환이 안될 때 몸이 보내는 신호 혈액 순환 방법 (0) | 2023.05.12 |
| 혈관을 망가뜨리는 음식 / 혈관에 안좋은 음식 (1) | 2023.05.10 |
| 사과식초 효능 5가지와 사과식초 섭취 방법 (1) | 2023.05.10 |



